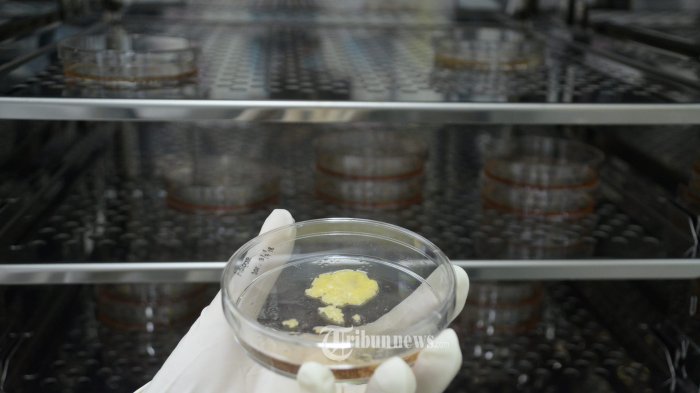

Imbas Pandemi COVID-19, Penelitian Bidang Perawatan Regeneratif Sel Punca Diprediksi Berkembang
Perawatan Stem Cell diharapkan akan menjadi sebuah teknologi perawatan sel generasi baru yang mampu mengatasi berbagai penyakit.
Teknologi platform sel punca dari Daewoong Pharmaceutical telah diakui oleh para ahli karena mutunya dan perusahaan senantiasa membuka kesempatan untuk berkolaborasi secara terbuka di dalam negeri maupun internasional.
Kolaborasi terbuka mengacu pada strategi inovasi terbuka untuk menggabungkan ide dan teknologi melalui kerja sama dengan para ahli di bidang tertentu, mitra bisnis, dan pemerintah.
“Kerja sama penelitian klinis merupakan faktor penentu keberhasilan dalam pengembangan perawatan sel punca. Kami bercita-cita memimpin pengembangan obat baru di bidang perawatan sel/genetik untuk meningkatkan kualitas hidup melalui penelitian bersama dengan para peneliti sel punca dari berbagai bidang dengan mempertahankan produk growth factors, teknologi budidaya sel punca, dan peralatan GMP yang memiliki permintaan tinggi,” kata Jeon Seung-ho.
Daewoong Infion memimpin industri farmasi dengan 'DWP710,' perawatan untuk gejala dispnea COVID-19 menggunakan DW-MSC
CEO Daewoong Infion, Chang-woo Suh mengatakan, usaha joint venture Daewoong Group di Indonesia, mengumumkan dimulainya uji klinis 'DWP710,' sebuah perawatan untuk gejala dispnea COVID-19 menggunakan 'DW-MSC,' sebuah teknologi independen terkait sel induk.
"Perawatan COVID-19berbasis sel induk bernama 'DWP710' ini telah memasuki proses uji klinis melalui kick of meeting kami dengan Kementerian Kesehatan pada tanggal 13 Agustus 2020," ujar Nova Angginy, kepala peneliti di Daewoong Infion.
Daewoong Infion memberikan penjelaskan protokol klinis 'DWP710' dan teknologi sel induk Daewoong Group 'DW-MSC' serta memberikan alat pelindung untuk mendukung perawatan COVID-19 pada pertemuan tersebut.
'DW-MSC' adalah teknologi canggih dari Daewoong Group yang mampu memperkuat efek sel punca, memanfaatkan bahan bebas serum dan bebas xeno dalam proses budidaya sel punca mesenkim.
Perawatan ini telah terbukti mampu mengobati infeksi dan peradangan akibat virus, bakteri, dan luka melalui berbagai penilaian kemampuan inflamasi.
Daewoong Infion akan memasuki uji klinis fase 2 untuk 'DWP710' pada kuartal pertama tahun 2021.
Di bawah otorisasi darurat berdasarkan kerja sama aktif bersama dengan Kementerian Kesehatan di Indonesia, Daewoong Infion berencana untuk segera mendistribusikan perawatan ini setelah menyelesaikan fase 2 uji klinis dalam rangka mengatasi COVID-19.
Daewoong Infion telah diberikan izin untuk menjalankan uji klinis fase 1 untuk 'DWP710' bulan lalu, dan telah terpilih sebagai proyek kerjasama Kementerian Kesehatan pada tanggal 6.
Uji klinis dilakukan di rumah sakit 'RSUP Dr. Wahidin Sudirohusodo', yang merupakan rumah sakit spesialisasi perawatan COVID-19 dengan berbagai pengalaman uji klinis global di bidang farmasi, dan akan merekrut pasien mulai minggu ketiga bulan Agustus 2020 untuk menyelesaikan hasil uji klinis fase 1 pada bulan Oktober 2020. Perusahaan berencana untuk mengajukan proposal uji klinis fase 2 di Korea dan Indonesia.
Daewoong Infion memutuskan untuk melakukan penelitian dan pengembangan perawatan COVID-19 lainnya selain 'DWP710', yaitu 'Niclosamide' dan 'Camostat' melalui kerja sama dengan rumah sakit 'RSUP Dr. Wahidin Sudirohusodo'. Kedua produk tersebut dilakukan untuk mengantisipasi efek pada pengobatan pasien COVID-19 ringan dan berat.
Antisipasi untuk pengobatan regeneratif pada kerusakan tulang dengan perangkat medis protein pembentuk tulang